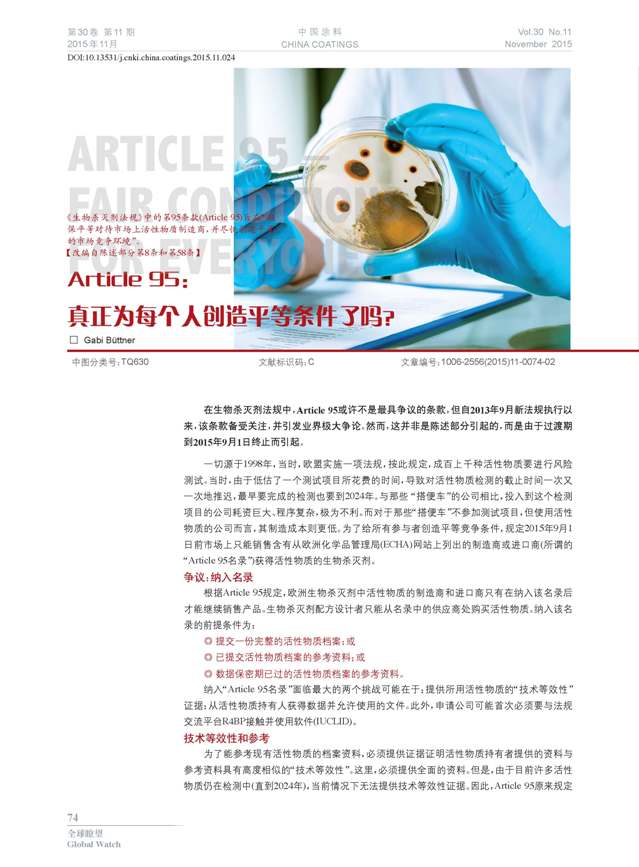
頁面提取自－1-76-24.jpg

Article 95:真正為每個人創(chuàng)造平等條件了嗎?
摘要:在生物殺滅劑法規(guī)中,Article 95或許不是最具爭議的條款,但自2013年9月新法規(guī)執(zhí)行以來,該條款備受關(guān)注,并引發(fā)業(yè)界極大爭論。然而,這并非是陳述部分引起的,而是由于過渡期到2015年9月1日終止而引起。
本文系作者@Gabi Büttner 授權(quán)中國涂料網(wǎng)發(fā)表,并經(jīng)中國涂料網(wǎng)編輯,未經(jīng)允許不得轉(zhuǎn)載,如需轉(zhuǎn)載請聯(lián)系chinacoatingnet@vip.163.com